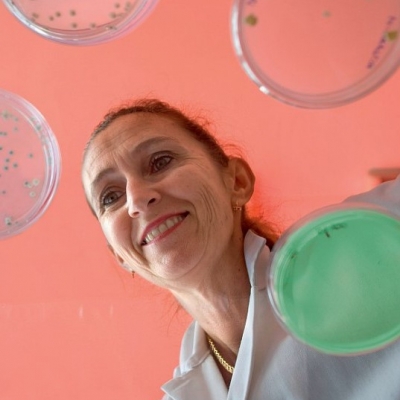
VALÉRIE MIZRAHI

Laureates of the L’Oréal-UNESCO For Women in Science International Award
The For Women in Science program empowers brilliant women scientists by rewarding and promoting their outstanding research and raising their profile at a global level. 137 Laureates have been awarded since 1998.
-
![Barbara FINLAYSON-PITTS]() Professor Barbara Finlayson-Pitts
Professor Barbara Finlayson-Pitts
Laureate 2025 for NORTH AMERICADistinguished Professor Emerita, Chemistry Department and Founder/Co-Director, Atmospheric Integrated Research Institute, University of California, Irvine, United States of America.Rewarded for her groundbreaking research revealing new processes in the formation of air pollution as photochemical smog, she established the molecular basis of reactions at the interfaces between atmosphere and airborne particles. Her unique ability to translate fundamental findings into real-life applications have led to seminal contributions to public policy and regulations on atmospheric chemistry, ultimately improving air quality. Her enthusiasm made her a passionate and remarkable professor and mentor. -
![Claudia FELSER]() Professor Claudia Felser
Professor Claudia Felser
Laureate 2025 for EUROPEDirector and Scientific Member, Max Planck Institute for Chemical Physics of Solids, Dresden, GermanyRewarded for her pioneering work at the crossroads of physics, mathematics and chemistry that led to the discovery and creation of new magnetic materials with great promise for future green energy technologies. Her visionary approach has paved the way for the new field of “topological quantum chemistry” and sparked a revolution in the field of relativistic matter. Her outstanding dedication and impact have built a bridge from fundamental science to real-world challenges in data storage and green energy technologies. She is a leading figure in communicating the relevance of science to the public, including by encouraging and mentoring young generations, especially women, to pursue a career in science. -
![Maria Teresa DOVA]() Professor María Teresa Dova
Professor María Teresa Dova
Laureate 2025 for LATIN AMERICA AND THE CARIBBEANProfessor at Physics Department, Faculty of Exact Sciences, National University of La Plata, and Senior Researcher at National Scientific and Technical Research Council (CONICET), La Plata, ArgentinaRewarded for her key contributions to high energy physics including the discovery and characterization of the Higgs boson, the search for new physics and her remarkable work in the study of cosmic ray physics. Her leadership in the field and her exceptional dedication to mentoring young scientists have inspired a new generation and led Argentina to play a major role in experimental physics worldwide. -
![Priscilla BAKER]() Professor Priscilla Baker
Professor Priscilla Baker
Laureate 2025 for AFRICA AND THE ARAB STATESProfessor of Chemistry, University of the Western Cape, Cape Town, South AfricaRewarded for her outstanding contribution in the field of highly sensitive electrochemical microsensors for detecting contaminants in the environment, with applications in pharmaceuticals, food, health and energy. Her dedication as a mentor in analytical electrochemistry has empowered students and early-career scientists to undertake innovative research projects in this field. -
![Xiaoyun WANG]() Professor Xiaoyun Wang
Professor Xiaoyun Wang
Laureate 2025 for ASIA AND THE PACIFICChen-Ning Yang Professorship, Institute for Advanced Study, Tsinghua University, Beijing, ChinaRewarded for her significant contribution to cryptography and cryptographic mathematics, critical for secure data communication and storage. Her breakthrough work showed essential flaws on hash functions, which are widely used in communication protocols and led to the invention of the new hash function standards. Today, these standards are used for bank cards, computer passwords, and e-commerce. The visibility of her revolutionary work has encouraged many female students to pursue a research career in mathematics and network security. -
![]() Professor Alicia Kowaltowski
Professor Alicia Kowaltowski
Laureate 2024 for LATIN AMERICA AND THE CARIBBEANProfessor of Biochemistry, University of São Paulo, BrazilShe is rewarded for her fundamental contribution to the biology of mitochondria, which are "the cell’s main energy source, acting as their batteries". Her work has been critical for our understanding of the implication of energy metabolism in chronic diseases, including obesity and diabetes, as well as in ageing. Her outstanding contribution as an investigator and mentor, as well as her advocacy for science in Latin America and its dissemination to the public, are an inspiration for young scientists. -
![]() Professor Geneviève Almouzni
Professor Geneviève Almouzni
Laureate 2024 for EUROPEDirector of Research from The National Centre for Scientific Research (CNRS) at the Curie Institute, Member of the Academy of Sciences, FranceShe is rewarded for her seminal contributions to understanding how DNA is packaged with proteins inside the cell nucleus. Her pioneering work in epigenetics has furthered our understanding of how cell identity is determined during normal development and disrupted by cancer. Her extraordinary successes in advancing research, training the next generation of scientists and promoting women in science are inspirational. -
![Pr Nada Jabado]() Professor Nada Jabado
Professor Nada Jabado
Laureate 2024 for NORTH AMERICAProfessor, Departments of Pediatrics and Human Genetics, Canada Research Chair Tier 1 in Pediatric Oncology, McGill University, CanadaShe is rewarded for revolutionizing our comprehension of the genetic defects responsible for aggressive pediatric brain tumours. Her seminal discovery of the first-ever histone mutations in human disease, referred to as oncohistones, has sparked a fundamental change in the cancer research sphere. Through her innovative research and effective leadership in establishing a global collaborative network, she has reshaped the medical approach to pediatric cancer, advancing both diagnostic capabilities and clinical treatments for young patients. -
![]() Professor Nieng Yan
Professor Nieng Yan
Laureate 2024 for ASIA AND THE PACIFICUniversity Professor, School of Life Sciences, Tsinghua University; Founding President of Shenzhen Medical Academy of Research and Translation; Director of Shenzhen Bay Laboratory, ChinaShe is rewarded for discovering the atomic structure of multiple membrane proteins that mediate the traffic of ions and sugars across the cell membrane, revealing principles that govern cross-membrane transport. Her exceptional research has informed multiple disorders such as epilepsy and arrhythmia and guided the treatment of pain syndrome. As a leading authority in her field, Dr Yan inspires female scientists globally and is a strong advocate for gender equality in research and science education. -
![]() Professor Rose Leke
Professor Rose Leke
Laureate 2024 for AFRICA AND THE ARAB STATESFormer Head of the Department of Infectious Diseases and Immunology, Faculty of Medicine and Biomedical Sciences, and Former Director of the Biotechnology Centre, University of Yaoundé 1, CameroonShe is rewarded for her dedicated leadership, outstanding research and pioneering efforts to improve outcomes in pregnancy-associated malaria, support the eradication of polio and improve immunization in Africa, as well as for her efforts to improve the career path of young scientists. Dr Leke’s national, regional, and global influence has had a profound impact on public health in her native Cameroon and across Africa. Her achievements position her as a role model, leading educator and advocate for young female scientists. -
![Professor Anamaría Font - Laureate LATAM]() PROFESSOR ANAMARÍA FONT
PROFESSOR ANAMARÍA FONT
Laureate 2023 for LATIN AMERICA AND THE CARIBBEANProfessor of Physics, Central University of Venezuela.
Prof. Anamaría Font is recognized for her work in theoretical particle physics, with a particular focus on developing the theory of superstrings. This describes, in a unified and consistent way, the elementary particles of nature. Her research has enabled further understanding of the theory’s consequences for the structure of matter and quantum gravity, which are also relevant to the description of black holes and the first moments after the big bang. -
![Professor Aviv Regev - Laureate North America]() PROFESSOR AVIV REGEV
PROFESSOR AVIV REGEV
Laureate 2023 for NORTH AMERICAExecutive Vice President and Global Head of Genentech Research and Early Development, Genentech/Roche, San Francisco.
Prof. Aviv Regev is awarded for her pioneering work applying mathematics and computer science to revolutionize cell biology. Her research enables scientists to discover and characterize the trillions of cells within the body and enhances our ability to decipher and target the mechanisms that cause disease, in order to develop better diagnostics and therapies.
-
![Professor Frances Kirwan - LAUREATE FOR EUROPE]() PROFESSOR FRANCES KIRWAN
PROFESSOR FRANCES KIRWAN
Laureate 2023 for EUROPESavilian Professor of Geometry, University of Oxford.
Prof. Frances Kirwan is rewarded for her exceptional work in pure mathematics combining geometry and algebra in order to develop techniques to understand the classification of geometric objects. These techniques have been used by theoretical physicists searching for mathematical descriptions of our universe. Her recent work has the potential to help scientists to extract crucial information from large complex data sets.
-
![Professor Lidia Morawska - LAUREATE ASIA]() PROFESSOR LIDIA MORAWSKA
PROFESSOR LIDIA MORAWSKA
Laureate 2023 for ASIA AND THE PACIFICDistinguished Professor, School of Earth Sciences and Climate, Queensland University of Technology, Australia and Director of the International Laboratory for air quality and health.
Prof. Lidia Morawska is distinguished for her excellent research in the field of air pollution and its impact on human health and the environment, with a specific focus on atmospheric particulate matter. Her extraordinary dedication and impact have built a bridge from fundamental science to real-world policy and practice to provide clean air for all.
-
![Professor Suzana Nunes - LAUREAT FOR AFRICA AND THE ARAB STATES]() Professor Suzana Nunes
Professor Suzana Nunes
Laureate 2023 for AFRICA AND THE ARAB STATESProfessor of Chemical and Environmental Science and Engineering, Vice Provost for Faculty and Academic Affairs, King Abdullah University of Science and Technology (KAUST), Saudi Arabia.
Prof. Suzana Nunes is awarded for her outstanding work in developing innovative membrane filters to achieve highly efficient chemical separations with a lower carbon footprint. Her research has proven to be particularly beneficial to the water, petrochemical and pharmaceutical industries in achieving a more sustainable environment. -
![Professor Agnès Binagwaho]() Professor Agnès Binagwaho
Professor Agnès Binagwaho
Laureate 2022 for AFRICA AND THE ARAB STATESProfessor of Pediatrics and Vice-Chancellor of the University of Global Health Equity, Kigali, Rwanda.Awarded for her central role in expanding access to public healthcare for the most vulnerable communities in Rwanda, Africa and beyond, helping reduce the global burden of disease and improving lives.
In particular, she focuses on best practices in building resilient health systems and improving the quality, availability, and affordability of healthcare services for people suffering with diseases including HIV, malaria, and tuberculosis. This has never been more important than now as overwhelmed healthcare systems across the world struggle to build back stronger in the wake of the Covid-19 pandemic.
-
![Professor Ángela Nieto]() Professor Ángela Nieto
Professor Ángela Nieto
Laureate 2022 for EUROPEProfessor at the Institute of Neuroscience (CSIC-UMH), San Juan de Alicante, Spain.Awarded for her fundamental discoveries in embryonic development, which have paved the way for understanding how cancer extends to other organs and forms metastases, the secondary tumours that cause more than 90% of cancer-related deaths.
In particular, she explores how cells change identity in the embryo to disseminate and form different tissues. This in turn stands to illuminate how cancer spreads and inform better therapeutic strategies.
-
![PROFESSEURE HAILAN HU]() Professor Hailan Hu
Professor Hailan Hu
Laureate 2022 for ASIA AND THE PACIFICProfessor and Executive Director of the Neuroscience Centre of Zhejiang University School of Medicine, China.Awarded for her major discoveries in social and emotional neuroscience. Her ground-breaking work has revolutionized scientific understanding of mental health and, deciphered the mechanism of depression to inform innovative treatment strategies and new medicines. These breakthroughs are vital in the wake of the mental health crisis sparked by the Covid-19 pandemic, with nearly 30% of the global population suffering from depression according to Lancet.
She is passionate about raising awareness and illuminating pathways to high impact solutions, particularly given that in many parts of the world, the illness remains largely under diagnosed and still taboo.
-
![Professor Katalin Karikó]() Professor Katalin Karikó
Professor Katalin Karikó
Laureate 2022 for NORTH AMERICAAdjunct Professor at the Perelman School of Medicine, University of Pennsylvania, and Senior Vice President at BioNTech RNA PharmaceuticalsAwarded for her ground-breaking development of a non-inflammatory mRNA, as a potent vaccine to prevent viral and parasitic infections. Her research has contributed to the development of the COVID-19 vaccines by Pfizer-BioNTech and Moderna.
She has been conducting years of research which led to a solution for one of the basic problems of RNA, namely the low and short-lived protein production. Professor Karikó discovered that nucleoside-modified mRNA – compared to unmodified and non-optimized mRNA – had a better tolerability and could be administered at higher doses.
Her research has paved the way for future therapies in complex diseases such as cancer, heart failure, stroke, anaemia, and autoimmune diseases.
-
![Professor Maria Guadalupe Guzmán]() Professor Maria Guadalupe Guzmán
Professor Maria Guadalupe Guzmán
Laureate 2022 for LATIN AMERICA AND THE CARIBBEANDirector of the Center for Research, Diagnostic and Reference activity of the Institute of Tropical Medicine, Pedro Kouri (IPK), Havana, Cuba.Awarded for her pioneering work to address the devastating human infections caused by the dengue virus, one of the world's most serious diseases in terms of morbidity and mortality, causing 390 million dengue virus infections annually¹.
Her research has led to a better understanding of its pathogenesis and risk factors, the origin of several epidemics of dengue haemorrhagic fever, the development of diagnosis and monitoring, and the search for potential new vaccines. It will also strengthen training for medical students and personnel, helping to ensure the next generations are better equipped to fight these viruses.
-
![Kyoko Nozaki, Unesco Laureates 2021]() KYOKO NOZAKI
KYOKO NOZAKI
Laureate 2021 for ASIA AND THE PACIFICProfessor of Chemistry at the University of Tokyo (Japan).Awarded for her pioneering, creative contributions within the field of synthetic chemistry, and their importance to industrial innovation.
Her research has led to new, highly effective and environmentally friendly production processes to manufacture molecules useful for medicine and sustainable agriculture.
-
![Alicia Dickenstein, Unesco Laureates 2021]() ALICIA DICKENSTEIN
ALICIA DICKENSTEIN
Laureate 2021 for LATIN AMERICA AND THE CARIBBEANProfessor of Mathematics at the University of Buenos Aires (Argentina).Awarded for her outstanding contributions at the forefront of mathematical innovation by leveraging algebraic geometry in the field of molecular biology. Her research enables scientists to understand the precise structures and behavior of cells and molecules, even at a microscopic scale. Operating at the frontier between pure and applied mathematics, she has forged important links to physics and chemistry, and enabled biologists to gain an in-depth structural understanding of biochemical reactions and enzymatic networks.
-
![Catherine Ngila, Unesco Laureates 2021]() CATHERINE NGILA
CATHERINE NGILA
Laureate 2021 for AFRICA AND THE ARAB STATESActing Executive Director of the African Academy of Sciences, Former Deputy Vice Chancellor in charge of Academic and Student Affairs at Riara University, Kenya, and Visiting Professor of Applied Chemistry at the University of Johannesburg (South Africa).Awarded for introducing and developing nanotechnology based analytical methods for the monitoring of water pollutants and applying them in countries heavily impacted by pollution. Her innovative work is of vital importance for the development of sustainable water resource management, respecting the environment.
-
![]() FRANÇOISE COMBES
FRANÇOISE COMBES
Laureate 2021 for EUROPEProfessor and Galaxies and Cosmology Chair at the Collège de France in Paris, and Astrophysicist at the Paris Observatory - PSL (France).Awarded for her outstanding legacy in astrophysics which ranges from the discovery of molecules in the interstellar space to supercomputer simulations of galaxy formation. Her work has been crucial in our understanding of the birth and evolution of stars and galaxies, including the role played by supermassive black holes at galactic centers.
-
![]() SHAFI GOLDWASSER
SHAFI GOLDWASSER
Laureate 2021 for NORTH AMERICADirector of the Simons Institute for the Theory of Computing, Professor in Electrical Engineering and Computer Sciences at University of California, RSA Professor Computer Science in USA and Professor of Computer Science and Applied Mathematics (Israel).Awarded for her pioneering and fundamental work in computer science and cryptography, essential for secure communication over the internet as well as for shared computation on private data. Her research has a significant impact on our understanding of large classes of problems for which computers cannot efficiently find approximate solutions.
-
![]() Alba Mehio Sibai
Alba Mehio Sibai
Laureate 2020 for AFRICA AND THE ARAB STATESProfessor of Epidemiology and Public Health Sciences, American University of Beirut (Lebanon).For her pioneering research and advocacy to improve healthy ageing in low- and middle-income countries and their impact on health and social policy programs.
-
![Edith Heard, Laureate For Women in Science International 2020]() Edith Heard
Edith Heard
Laureate 2020 for EUROPEDirector General of the European Molecular Biological Sciences Laboratory, Professor and Chair of Epigenetics and Cellular Memory at the Collège de France (France).For her fundamental discoveries concerning the mechanisms governing epigenetic processes, which allow mammals to regulate proper gene expression and are essential for life.
-
![Esperanza Martinez Romero, For Women in Science International 2020]() Esperanza Martinez Romero
Esperanza Martinez Romero
Laureate 2020 for LATIN AMERICA AND THE CARIBBEANProfessor of Environmental Science, Genomic Science at the Center of the National Autonomous University of Mexico (Mexico).For her pioneering work on the use of environmentally friendly bacteria to support plant growth for increased agricultural productivity and reduced use of chemical fertilizers.
-
![Firdausi Qadri, Laureate For Women in Science International 2020]() Firdausi Qadri
Firdausi Qadri
Laureate 2020 for ASIA AND THE PACIFICSenior Director, Infectious Diseases Division, International Center for Diarrhoeal Disease and Research, Dhaka (Bangladesh).For her outstanding work to understand and prevent infectious diseases affecting children in developing countries, and promote early diagnosis and vaccination with global health impact.
-
![KRISTI ANSETH, Laureate For Women In Science International 2020]() Kristi Anseth
Kristi Anseth
Laureate 2020 for NORTH AMERICADistinguished Professor, Tisone Professor, Associate Professor of Surgery, University of Colorado, Boulder (United States of America).For her outstanding contribution in Converging Engineering and Biological Sciences to develop innovative biomaterials that help tissue regeneration and drug delivery.
-
![Claire Voisin]() Claire Voisin
Claire Voisin
Laureate 2019 for EUROPEDirector at CNRS, Institute of Mathematics of Jussieu - Professor, Chair of Algebraic Geometry at the Collège de France (France).For her outstanding work in Algebraic Geometry.
-
![INGRID DAUBECHIES]() Ingrid Daubechies
Ingrid Daubechies
Laureate 2019 for NORTH AMERICAProfessor of Mathematics and Electrical and Computer Engineering, Duke University (United States).For her outstanding contribution to digital images and signal processing, providing common and versatile algorithms for data compression.
-
![KAREN HALLBERG FWIS 2019]() Karen Hallberg
Karen Hallberg
Laureate 2019 for LATIN AMERICA AND THE CARIBBEANProfessor of Physics at the Balseiro Institute and Research Director at the Bariloche Atomic Centre, CNEA/CONICET (Argentina).For developing cutting-edge computational approaches that allow scientists to understand the physics of quantum matter.
-
![MAKI KAWAI FWIS 2019]() Maki Kawai
Maki Kawai
Laureate 2019 for ASIA AND THE PACIFICDirector General, Institute for Molecular Science, University of Tokyo, Japan, member of the Science Council of Japan, President of the Chemical Society of Japan (Japan).For her ground-breaking work in manipulating molecules at the atomic level, in order to transform materials and create innovative materials.
-
![NAJAT AOUN SALIBA FWIS 2019]() Najat Aoun Saliba
Najat Aoun Saliba
Laureate 2019 for AFRICA AND THE ARAB STATESProfessor of Chemistry and Director of the Nature Conservation Center at the American University of Beirut (Lebanon).For her pioneering work in identifying carcinogenic agents and other toxic air pollutants the in Middle East, and in modern nicotine delivery systems, such as cigarettes and hookahs.
-
![AMY AUSTIN]() Amy Austin
Amy Austin
Laureate 2018 for LATIN AMERICA AND THE CARIBBEANProfessor, IFEVA-CONICET, Faculty of Agronomy, University of Buenos Aires (Argentina).For her remarkable contributions to understanding terrestrial ecosystem ecology in natural and human-modified landscapes.
-
![DAME CAROLINE DEAN]() Dame Caroline Dean
Dame Caroline Dean
Laureate 2018 for EUROPEProfessor, John Innes Centre, Norwich Research Park, (United Kingdom).For her groundbreaking research on how plants adapt to their surroundings and climate change, leading to new ways to improve crops.
-
![HEATHER ZAR]() Heather Zar
Heather Zar
Laureate 2018 for AFRICA AND THE ARAB STATESProfessor and Chair, Department of Paediatrics & Child Health Sciences, Red Cross War Memorial Children’s Hospital, Director SAMRC Unit, University of Cape Town (South Africa).For establishing a cutting-edge research programme on pneumonia, tuberculosis and asthma, saving the lives of many children worldwide.
-
![JANET ROSSANT]() Janet Rossant
Janet Rossant
Laureate 2018 for NORTH AMERICASenior Scientist, The Hospital for Sick Children, Toronto, Canada Professor, University of Toronto, Canada, President, Gairdner Foundation, Director, Ontario Institute for Regenerative Medicine (Canada).For her outstanding research that helped to understand better how tissues and organs are formed in the developing embryo.
-
![MEEMANN CHANG]() Meemann Chang
Meemann Chang
Laureate 2018 for ASIA AND THE PACIFICProfessor, Institute of Vertebrate Palaeontology and Palaeoanthropology Member of Chinese Academy of Sciences, Beijing (China).For her pioneering work on fossil records leading to insights on how aquatic vertebrates adapted to life on land.
-
![MARIA TEREZA RUIZ]() Maria Tereza Ruiz
Maria Tereza Ruiz
Laureate 2017 for LATIN AMERICA AND THE CARIBBEANProfessor, Department of Astronomy, Universidad of Chile (Chile).For her contributions to the study of a variety of faint celestial objects hidden in the darkness of the universe.
-
![MICHELLE SIMMONS]() Michelle Simmons
Michelle Simmons
Laureate 2017 for ASIA AND THE PACIFICProfessor and Director of the Center of Excellence for Quantum Computation and Communication Technology, University of New South Wales (Australia).For pioneering ultra-fast quantum computers.
-
![NICOLA SPALDIN]() Nicola Spaldin
Nicola Spaldin
Laureate 2017 for EUROPEProfessor and Chair of Materials Theory, ETH Zürich (Switzerland).For reinventing magnetic materials for next-generation Material Engineering devices.
-
![NIVEEN KHASHAB]() Niveen Khashab
Niveen Khashab
Laureate 2017 for AFRICA AND THE ARAB STATESAssociate Professor of Chemical Sciences and Engineering, King Abdullah University of Science and Technology (KAUST) (Saudi Arabia).For designing novel nanoparticles that could improve early detection of disease.
-
![ZHENAN BAO]() Zhenan Bao
Zhenan Bao
Laureate 2017 for NORTH AMERICAProfessor of Chemical Engineering and Material Science and Engineering, Stanford University (United States). ).For inventing skin-inspired Material Engineering materials.
-
![ANDREA GAMARNIK]() Andrea Gamarnik
Andrea Gamarnik
Laureate 2016 for LATIN AMERICA AND THE CARIBBEANProfessor, Molecular Virology Laboratory, Fundación Instituto Leloir, CONICET, Buenos Aires (Argentina).For her seminal discoveries on how mosquito-borne viruses reproduce and cause human diseases, particularly Dengue Fever.
-
![EMMANUELLE CHARPENTIER]() Emmanuelle CHARPENTIER
Emmanuelle CHARPENTIER
Laureate 2016 for EUROPEProfessor and researcher in microbiological Sciences, Genetics and Biochemistry, Director of the Max Planck Institute for Infection Biological Sciences, Berlin (Germany).For her game-changing discovery, alongside Professor Emmanuelle CHARPENTIER, of a versatile DNA editing technique to “rewrite” flawed genes in people and other living organisms, opening tremendous new possibilities for treating, even curing, diseases.
-
![HUALAN CHEN]() Hualan Chen
Hualan Chen
Laureate 2016 for ASIA AND THE PACIFICMember of the World Organisation for Animal Health Sciences (OIE), member of the Food and Agriculture Organization Corporate Statistical Database (FAOSTAT), Reseacher and PhD Supervisor at Harbin Veterinary Research Institute of Chinese Academy, (China).For her outstanding research into the biology of the bird flu virus, leading to the development and use of an effective vaccine.
-
![JENNIFER DOUDNA]() Jennifer Doudna
Jennifer Doudna
Laureate 2016 for NORTH AMERICALi Ka Shing Chancellor Chair Professor, Department of Chemistry and Department of Molecular and Cell Biological Sciences, University of California, Berkeley (United States). ).For her game-changing discovery, alongside Professor Emmanuelle Charpentier, of a versatile DNA editing technique to “rewrite” flawed genes in people and other living organisms, opening tremendous new possibilities for treating, even curing, diseases.
-
![QUARRAISHA ABDOOL KARIM]() QUARRAISHA Abdool Karim
QUARRAISHA Abdool Karim
Laureate 2016 for AFRICA AND THE ARAB STATESAssociate Scientific Director of the AIDS research center, CAPRISA, Professor in Clinical Epidemiology at the Columbia University, honorary professor in Public Health Sciences at the University of KwaZulu-Natal, (South Africa).For her remarkable contribution to the prevention and treatment of HIV and associated infections, greatly improving the quality of life of women in Africa.
-
![CAROL ROBINSON]() Carol Robinson
Carol Robinson
Laureate 2015 for EUROPEChemist and President of the Royal Society of Chemistry, Royal Society Reseacher Professor at the Physical and Theoretical Chemistry Laboratory at the University of Oxford (United Kingdom).For her groundbreaking work in macromolecular mass spectrometry and pioneering gas phase structural biology by probing the structure and reactivity of single proteins and protein complexes, including membrane proteins.
-
![MOLLY SHOICHET]() Molly Shoichet
Molly Shoichet
Laureate 2015 for EUROPEProfessor, Chemistry and biomedical engineering at Toronto University Head of the research program Shoichetlab specialized to the regenerative medecine (Canada).For her pioneering work on advanced laser photochemistry for creating 3D patterns in hydrogels that enable regeneration of nerve tissue. In addition, she established a new method to deliver biotherapeutics to the central nervous system, overcoming the blood-brain barrier.
-
![RAJAA CHERKAOUI EL MOURSLI]() Rajaa CHERKAOUI EL MOURSLI
Rajaa CHERKAOUI EL MOURSLI
Laureate 2015 for AFRICA AND THE ARAB STATESProfessor of nuclear physics at Mohammed V's Rabat University (Marocco).For her key contribution to one of the greatest discoveries in physics: proof of the existence of the Higgs Boson, the particle responsible for the creation of mass in the universe.
-
![THAISA BERGMANN]() Thaisa BERGMANN
Thaisa BERGMANN
Laureate 2015 for LATIN AMERICA AND THE CARIBBEANPresident of Cross-Division D-J Commission Supermassive Black Holes, Feedback and Galaxy Evolution at UFGRS / Head of Research Group Department of Astronomy - IF-UFRGS (Brazil).For her outstanding work on super-massive black holes in the centers of galaxies and their associated regions of dense gas, dust, and young stars surrounding them, as well as their role in the evolution of galaxies.
-
![YI XIE]() Yi Xie
Yi Xie
Laureate 2015 for ASIA AND THE PACIFICChemist, member of the Chinese Academy of Sciences and a fellow of the Royal Society of Chemistry, professor and doctoral supervisor at University of Science and Technology of China (China).For her significant contributions to inorganic solid state solvothermal chemistry at the nanoscale, particularly unconventional semi-conductor materials and graphene-like structures a few atoms thick.
-
![BRIGITTE KIEFFER]() Brigitte Kieffer
Brigitte Kieffer
Laureate 2014 for EUROPEProfessor at Strasbourg Univercity, Director of INSERM at Strasbourg and Institut Douglas at Montreal (France).For her decisive work on the brain mechanisms involved in pain, mental illness and drug addiction.
-
![CECILA BOUZAT]() Cecila BOUZAT
Cecila BOUZAT
Laureate 2014 for LATIN AMERICA AND THE CARIBBEANPrincipal Investigator of the CONICET and Deputy Director of the Institute of Biochemical Research of White Bay (INIBIBB), (Argentina).For her contribution to our understanding of how brain cells communicate among themselves and with muscles.
-
![LAURIE GLIMCHER]() Kayo Inaba
Kayo Inaba
Laureate 2014 for ASIA AND THE PACIFICDirector, Kyoto University Gender Equality Promotion Center / Executive Vice-President for Gender Equality, International Affairs, and Public Relations, Kyoto University/ Guest Investigator (Japan).For her critical discoveries concerning the mechanisms triggered by the immune system when it is faced with a threat such as a virus or bacteria or by abnormal cells such as cancer cells.
-
![LAURIE GLIMCHER]() Laurie Glimcher
Laurie Glimcher
Laureate 2014 for NORTH AMERICAPresident and CEO of Dana-Farber Cancer Institute, Member of the American Philosophical Society (United States).For discovering key factors involved in controlling immune response (T-bet) in allergies and in autoimmune, infectious and malignant diseases.
-
![SEGENET KELEMU]() Segenet Kelemu
Segenet Kelemu
Laureate 2014 for AFRICA AND THE ARAB STATESDirector General of the International Centre of Insect Physiology and Ecology, Director of Biosciences eastern and central Africa (BecA); Vice President of Programs at the Alliance for a Green Revolution in Africa (AGRA), and Leader of Crop, (Ethiopia).For her research on how microorganisms living in symbiosis with forage grasses can improve their capacity to resist disease and adapt to environmental and climate change.
-
![DEBORAH JIN]() Deborah JIN
Deborah JIN
Laureate 2013 for LATIN AMERICA AND THE CARIBBEANFor having been the first to cool down molecules so much that she can observe chemical reactions in slow motion which may help further understanding of molecular processes which are important for medicine or new energy sources.
-
![FRANCISCA OKEKE]() Francisca OKEKE
Francisca OKEKE
Laureate 2013 for AFRICA AND THE ARAB STATESProfessor of Physics at the University of Nigeria (Nigeria).For her significant contributions to the understanding of daily variations of the ion currents in the upper atmosphere which may further our understanding of climate change.
-
![MARCIA BARBOSA]() Marcia BARBOSA
Marcia BARBOSA
Laureate 2013 for LATIN AMERICA AND THE CARIBBEANFreelance Biogeography consulting nd training at Portugal (Brazil).For discovering one of the peculiarities of water which may lead to better understanding of how earthquakes occur and how proteins fold which is important for the treatment of diseases.
-
![PRATIBHA GAI]() Pratibha GAI
Pratibha GAI
Laureate 2013 for EUROPEMicroscopist and Professor and Chair of Electron Microscopy and former Director at The York JEOL Nanocentre, Departments of Chemistry and Physics, University of York (United Kingdom).For ingeniously modifying her electron microscope so that she was able to observe chemical reactions occurring at surface atoms of catalysts which will help scientists in their development of new medicines or new energy sources.
-
![REIKO KURODA]() Reiko KURODA
Reiko KURODA
Laureate 2013 for ASIA AND THE PACIFICForeign member of the Royal Swedish Academy of Sciences in its class for chemistry, Professor at the Department of Life Sciences at the University of Tokyo (Japan).For discovering the functional importance of the difference between left handed and right handed molecules which has wide applications including research on neurodegenerative diseases such as Alzheimer's.
-
![BONNIE BASSLER]() Bonnie BASSLER
Bonnie BASSLER
Laureate 2012 for NORTH AMERICAProfessor in Molecular Biological Sciences and chair of the Department of Molecular Biological Sciences at Princeton University (United States of America).For understanding the chemical communication between bacteria and opening new doors for treating infections.
-
![FRANCES ASHCROFT]() Frances ASHCROFT
Frances ASHCROFT
Laureate 2012 for EUROPERoyal Society GlaxoSmithKline Research Professor at the University Laboratory of Physiology at the University of Oxford (United Kingdom).For advancing our understanding of insulin secretion and of neonatal diabetes.
-
![INGRID SCHEFFER]() Ingrid SCHEFFER
Ingrid SCHEFFER
Laureate 2012 for ASIA AND THE PACIFICPaediatric neurologist and senior research fellow at the Florey Institute of Neuroscience and Mental Health Sciences (Australia).For identifying genes involved in some forms of epilepsy.
-
![JILL FARRANT]() Jill FARRANT
Jill FARRANT
Laureate 2012 for AFRICA AND THE ARAB STATESProfessor of Molecular and Cell Biological Sciences at the University of Cape Town (South Africa).For discovering how plants survive under dry conditions.
-
![SUSANA LÓPEZ]() Susana LÓPEZ
Susana LÓPEZ
Laureate 2012 for LATIN AMERICA AND THE CARIBBEANProfessor of virology at the Institute of Biotechnology at the National Autonomous University of Mexico (Mexico).For identifying how rotaviruses cause the death of 600,000 children each year.
-
![ANNE L'HUILLIER]() Anne L'HUILLIER
Anne L'HUILLIER
Laureate 2011 for EUROPEProfessor of atomic physic at Lund University in Sweden (Sweden).For her work on the development of the fastest camera for recording events in attoseconds (a billionth of a billionth of a second).
-
![FAIZA AL-KHARAFI]() Faiza AL-KHARAFI
Faiza AL-KHARAFI
Laureate 2011 for AFRICA AND THE ARAB STATESProfessor of chemistry at Kuwait University, member of the Board of Director of Kuwait University (Kuwait).For her work on corrosion, a problem of fundamental importance to water treatment and the oil industry.
-
![JILLIAN BANFIELD]() Jillian BANFIELD
Jillian BANFIELD
Laureate 2011 for NORTH AMERICAProfessor at the University of California, Berkeley with appointments in the Earth Science, Ecosystem Science and Materials Science and Engineering departments.For her work on bacterial and material behaviour under extreme conditions relevant to the environment and the Earth.
-
![SILVIA TORRES-PEIMBERT]() Silvia Torres-Peimbert
Silvia Torres-Peimbert
Laureate 2011 for LATIN AMERICA AND THE CARIBBEANPresident of the International Astronomical Union and member of the American Astronomical Society and the Academy of Sciences of the Developing World, (Mexico).For her work on the chemical composition of nebulae which is fundamental to our understanding of the origin of the universe.
-
![VIVIANNA WING-WAH YAM]() Vivianna WING-WAH YAM
Vivianna WING-WAH YAM
Laureate 2011 for ASIA AND THE PACIFICProfessor in chemistry and Energy at the University of Hong Kong (China).For her work on light-emitting materials and innovative ways of capturing solar energy.
-
![ALEJANDRA BRAVO]() Alejandra BRAVO
Alejandra BRAVO
Laureate 2010 for LATIN AMERICA AND THE CARIBBEANResearcher at the Institute of Molecular MicroBiological Sciences of the National Autonomous University of Mexico (UNAM) (Mexico).For her work on a bacterial toxin that acts as a powerful insecticide.
-
![ANNE DEJEAN]() Anne DEJEAN
Anne DEJEAN
Laureate 2010 for EUROPEResearch Director at INSERM and Professor at the Pasteur Institute, head of the Laboratory of Nuclear Organization and Oncogenesis at the Pasteur Institute and the INSERM Unit 993 Molecular and Cellular Biological Sciences of Tumors (France).For her contributions to our understanding of leukaemia and liver cancers.
-
![ELAINE FUCHS]() Elaine FUCHS
Elaine FUCHS
Laureate 2010 for NORTH AMERICAInvestigator at the Howard Hughes Medical Institute and the Rebecca C. Lancefield Professor of Mammalian Cell Biological Sciences and Development at The Rockefeller University (United States of America).For her contributions to our knowledge of skin Biological Sciences and skin stem cells.
-
![LOURDES CRUZ]() Lourdes CRUZ
Lourdes CRUZ
Laureate 2010 for ASIA AND THE PACIFICProfessor of Immunology, at the University of Phillipines Marine Science Institte, Founder of the rural Livehood Incubator in Bataan (Phillipines).For the discovery of marine snail toxins that can serve as powerful tools to study brain function.
-
![RASHIKA EL RIDI]() Rashika EL RIDI
Rashika EL RIDI
Laureate 2010 for AFRICA AND THE ARAB STATESProfessor of Immunology, Department of Zoology Faculty of Science, Cairo University (Egypt).For paving the way towards the development of a vaccine against the tropical disease schistosomiasis.
-
![AKIKO KOBAYASHI]() Akiko KOBAYASHI
Akiko KOBAYASHI
Laureate 2009 for ASIA AND THE PACIFICProfessor of chemistry emeritus at the University of Tokyo and Nihon University (Japan).For her contribution to the development of molecular conductors and the design and synthesis of a single-component molecular metal.
-
![ATHENE DONALD]() Athene DONALD
Athene DONALD
Laureate 2009 for EUROPEProfessor of Experimental Physics at the University of Cambridge and Master of Churchill College, Cambridge (United Kingdom).For her work in unraveling the mysteries of the physics of messy materials, ranging from cement to starch.
-
![BEATRIZ BARBUY]() Beatriz BARBUY
Beatriz BARBUY
Laureate 2009 for LATIN AMERICA AND THE CARIBBEANProfessor of astrophysics at the Instituto de Astronomia, Geofísica Ciências Atmosféricas (IAG) at the University of São Paulo, vice-president of the International Astronomical Union (IAU) (Brazil).For her work on the life of stars from the birth of the Universe to the present time.
-
![EUGENIA KUMACHEVA]() Eugenia KUMACHEVA
Eugenia KUMACHEVA
Laureate 2009 for NORTH AMERICAProfessor of Chemistry at the University of Toronto and a Canada Research Chair in Advanced Functional Materials (Canada).For the design and development of new materials with many applications including targeted drug delivery for cancer treatments and materials for high density optical data storage.
-
![TEBELLO NYOKONG]() Tebello NYOKONG
Tebello NYOKONG
Laureate 2009 for AFRICA AND THE ARAB STATESProfessor of Medical Chemistry and technology at Rhodes University, and a recipient of the Presidency of South Africa's Order of Mapungubwe in Bronze (South Africa).For her work on harnessing light for cancer therapy and for environmental clean-up.
-
![ADA YONATH]() Ada YONATH
Ada YONATH
Laureate 2008 for AFRICA AND THE ARAB STATESProfessor at the Hebrew University of Jerusalem Weizmann Institute of Science (Israel).For her structural studies of the protein biosynthesis system and its disruption by antibiotics.
-
![ANA BELEN ELGOYHEN]() Ana Belen ELGOYHEN
Ana Belen ELGOYHEN
Laureate 2008 for LATIN AMERICA AND THE CARIBBEANProfessor of Pharmacology at the University of Buenos Aires and independent researcher of the National Scientific and Technical Research Council (Argentina).For her contributions to the understanding of the molecular basis of hearing (sense).
-
![ELIZABETH BLACKBURN]() Elizabeth BLACKBURN
Elizabeth BLACKBURN
Laureate 2008 for NORTH AMERICAResearcher at molecular Biological Sciences at the University of California, member of the Institute of Medicine (United States).).For the discovery of the nature and maintenance of chromosome ends and their roles in cancer and aging.
-
![LIHADH AL-GAZALI]() Lihadh AL-GAZALI
Lihadh AL-GAZALI
Laureate 2008 for AFRICA AND THE ARAB STATESProfessor in Clinical Genetics and Paediatrics (UAE).For her contributions to the characterization of inherited disorders.
-
![V. NARRY KIM]() V. Narry KIM
V. Narry KIM
Laureate 2008 for ASIA AND THE PACIFICProfessor of biochemestry, cell Biological Sciences and Molecular Biological Sciences at Seoul National University (Korea).For elucidating the formation of a new class of RNA molecules involved in gene regulation.
-
![AMEENAH GURIB-FAKIM]() Ameenah GURIB-FAKIM
Ameenah GURIB-FAKIM
Laureate 2007 for AFRICA AND THE ARAB STATESFor her exploration and analysis of plants from Mauritius and their bio-medical applications.
-
![LIGIA GARGALLO]() Ligia GARGALLO
Ligia GARGALLO
Laureate 2007 for LATIN AMERICA AND THE CARIBBEANProfessor, Department of Physical Chemistry Pontifical Catholic University of Chile Santiago (Chile).For her contributions to understanding solution properties of polymers.
-
![MILDRED DRESSELHAUS]() Mildred DRESSELHAUS
Mildred DRESSELHAUS
Laureate 2007 for NORTH AMERICAFor her research on solid state materials, including conceptualizing the creation of carbon nanotubes.
-
![TATIANA BIRSHTEIN]() Tatiana BIRSHTEIN
Tatiana BIRSHTEIN
Laureate 2007 for ASIA AND THE PACIFICFor her contribution to the understanding of the shapes, sizes and motions of large molecules.
-
![CHRISTIANE NÜSSLEIN-VOLHARD]() Christiane NÜSSLEIN-VOLHARD
Christiane NÜSSLEIN-VOLHARD
Laureate 2006 for EUROPESince October 2014 Director Emeritus of Research Group "Colour Pattern Formation" at the Max Planck Institute of Developmental Biological Sciences, Tübingen (Germany).For her efforts in supporting highly qualified women with children to facilitate their progress in science.
-
![CHRISTINE VAN BROECKHOVEN]() Christine VAN BROECKHOVEN
Christine VAN BROECKHOVEN
Laureate 2006 for EUROPEResearch Project Investigator - Laboratory Director - Department director - VIB Department of Molecular Genetics Campus Drie Eiken University of Antwerp - UA Universiteitsplein 1 (Belgium).For her genetic investigations of Alzheimer’s and other neurodegenerative disorders.
-
![ESTHER OROZCO]() Esther OROZCO
Esther OROZCO
Laureate 2006 for LATIN AMERICA AND THE CARIBBEANProfessor, Patología Experimental Centro de Investigación y de Estudios Avanzados del Instituto Politécnico Nacional, Mexico City (Mexico).For her discovery of the mechanism and control of infections by amoebae in the tropics.
-
![HABIBA BOUHAMED CHAABOUNI]() Habiba BOUHAMED CHAABOUNI
Habiba BOUHAMED CHAABOUNI
Laureate 2006 for AFRICA AND THE ARAB STATESProfessor of Medical Genetics at University of Tunis (Tunisia).For her contribution to the analysis and prevention of hereditary disorders.
-
![JENNIFER GRAVES]() Jennifer GRAVES
Jennifer GRAVES
Laureate 2006 for ASIA AND THE PACIFICEmeritus Professor in molecullar science at Australian National University, Canberra Head, Comparative Genomics Research Group Director, ARC Centre for Kangaroo Genomics (Australia).For her studies on the evolution of mammalian genomes.
-
![PAMELA BJORKMAN]() Pamela BJORKMAN
Pamela BJORKMAN
Laureate 2006 for NORTH AMERICAMax Delbruck Professor of Biological Sciences and Investigator, Howard Hughes Medical Institute California Institute of Technology (CalTech) Pasadena, California (United States).For her discovery of how the immune system recognizes targets.
-
![BELITA KOILLER]() Belita KOILLER
Belita KOILLER
Laureate 2005 for LATIN AMERICA AND THE CARIBBEANProfessor of Physics at the Institute of Physics Federal University of Rio de Janeiro (Brazil).For her innovative theoretical research on electrons in disordered materials such as glass.
-
![DOMINIQUE LANGEVIN]() Dominique LANGEVIN
Dominique LANGEVIN
Laureate 2005 for EUROPECNRS Directeur de Recherches Laboratory of Solid State Physics, University of Paris-Sud, Orsay (France).For her fundamental investigations of detergents, emulsions and foams.
-
![FUMIKO YONEZAWA]() Fumiko YONEZAWA
Fumiko YONEZAWA
Laureate 2005 for ASIA AND THE PACIFICFor her pioneering theory and computer simulations of amorphous semiconductors and liquid metals.
-
![MYRIAM P. SARACHIK]() Myriam P. SARACHIK
Myriam P. SARACHIK
Laureate 2005 for NORTH AMERICADistinguished Emeritus Professor of Physics Department of Physics, City College of New York (CUNY), New York (United States). ).For important experiments on electrical conduction and the transition between metals and insulators.
-
![ZOHRA BEN LAKHDAR]() Zohra BEN LAKHDAR
Zohra BEN LAKHDAR
Laureate 2005 for AFRICA AND THE ARAB STATESProfessor of Physics Laboratory of Atomic-Molecular Spectroscopy and Applications, Faculty of Sciences, University of Tunis El Manar (Tunisia).For her experiments and models on infrared spectroscopy and its applications to pollution detection and medicine.
-
![CHRISTINE PETIT]() Christine PETIT
Christine PETIT
Laureate 2004 for EUROPEResearcher at Genetics of Sensory Defects Laboratory Institut Pasteur, Paris (France).For her elucidation of the genetic defects in hereditary deafness and other sensory disorders.
-
![JENNIFER THOMSON]() Jennifer THOMSON
Jennifer THOMSON
Laureate 2004 for AFRICA AND THE ARAB STATESProfessor at Department of Molecular and Cell Biological Sciences. University of Cape Town (South Africa).For her development of transgenic plants resistant to viral infections, drought, and other risks.
-
![LUCIA MENDONÇA PREVIATO]() Lucia MENDONÇA PREVIATO
Lucia MENDONÇA PREVIATO
Laureate 2004 for LATIN AMERICA AND THE CARIBBEANProfessor and Researcher of Biophysics Institute, Federal University of Rio de Janeiro (Brazil).For her achievements in the understanding, treatment and prevention of Chagas' disease.
-
![NANCY IP]() Nancy IP
Nancy IP
Laureate 2004 for ASIA AND THE PACIFICProfessor at Department of Biochemistry and Biotechnology Research Institute, Hong Kong University of Science and Technology, Hong Kong (China).For her discoveries on the molecular control of growth, differentiation, and synapse formation in the nervous system.
-
![PHILIPPA MARRACK]() Philippa MARRACK
Philippa MARRACK
Laureate 2004 for NORTH AMERICAProfessor at National Jewish Medical and Research Center, Denver, Colorado (United States). ).For her characterization of the functions of T lymphocytes in immunity and the discovery of super-antigens.
-
![AYSHA ERZAN]() Aysha ERZAN
Aysha ERZAN
Laureate 2003 for AFRICA AND THE ARAB STATESProfessor at Istanbul Technical University, Istanbul (Turkey).For her theoretical work on the formation of tree-like structures.
-
![FANG-HUA LI]() Fang-Hua LI
Fang-Hua LI
Laureate 2003 for ASIA AND THE PACIFICFor her discovery of novel techniques in electron microscopy.
-
![JOHANNA LEVELT SENGERS]() Johanna LEVELT SENGERS
Johanna LEVELT SENGERS
Laureate 2003 for NORTH AMERICAFor her experiments on critical opalescence in fluids.
-
![KARIMAT EL-SAYED]() Karimat EL-SAYED
Karimat EL-SAYED
Laureate 2003 for AFRICA AND THE ARAB STATESProfessor of Crystallography at Ain Shams University (Egypt).For her work on crystal growth, including the formation of kidney stones.
-
![MARIANNA WEISSMANN]() Marianna WEISSMANN
Marianna WEISSMANN
Laureate 2003 for LATIN AMERICA AND THE CARIBBEANProfessor at Argentine National Research Council, Buenos Aires (Argentina).For her theoretical studies on novel forms of carbon.
-
![ANA MARIA LOPEZ COLOMÉ]() Ana Maria LOPEZ COLOMÉ
Ana Maria LOPEZ COLOMÉ
Laureate 2002 for LATIN AMERICA AND THE CARIBBEANProfessor of biochemestry at the Institute of Cellular Physiology, National Autonomous University, Mexico City (Mexico).For her discoveries of the molecular pathways involved in vision and pathological alterations.
-
![INDIRA NATH]() Indira NATH
Indira NATH
Laureate 2002 for ASIA AND THE PACIFICProfessor at All India Institute of Medical Sciences, New Delhi - Former Founder Head of Department of Biotechnology at the All India Institute of Medical Sciences (India).For her fundamental contributions to the pathogeny, prevention and treatment of leprosy.
-
![MARIANNE GRUNBERG-MANAGO]() Marianne GRUNBERG-MANAGO
Marianne GRUNBERG-MANAGO
Laureate 2002 for EUROPEFor her lifetime achievements and exceptional participation in the development of modern molecular Biology.
-
![MARY OSBORN]() Mary OSBORN
Mary OSBORN
Laureate 2002 for EUROPEInternational Union of Biochemistry and Molecular Biological Sciences (IUBMB). Member of University of Göttingen Research Committee (Germany).For her development of immunofluorescence microscopy as a tool for the study of cytoskeletal structures.
-
![NAGWA MEGUID]() Nagwa MEGUID
Nagwa MEGUID
Laureate 2002 for AFRICA AND THE ARAB STATESResearcher at the National Research Center, Cairo (Egypt).For her systematic genetic investigations of Down syndrome and other neurological conditions in the Mediterranean region.
-
![SHIRLEY TILGHMAN]() Shirley TILGHMAN
Shirley TILGHMAN
Laureate 2002 for NORTH AMERICAPresident, Princeton University, New Jersey (United States).For her discovery of parental imprinting and its role in embryological development.
-
![ADEYINKA GLADYS FALUSI]() Adeyinka Gladys FALUSI
Adeyinka Gladys FALUSI
Laureate 2001 for AFRICA AND THE ARAB STATESProfessor of haematology at Institute for Medical Research & Training of the College of Medicine, University of Ibadan, Ibadan (Nigeria).For her molecular-genetic identification and classification of hereditary blood diseases in Africa.
-
![Fondation l'oréal logo]() Anne MC LAREN
Anne MC LAREN
Laureate 2001 for EUROPEFor her discoveries in reproductive Biology, which have paved the way to human assisted reproduction.
-
![JOAN STEITZ]() Joan STEITZ
Joan STEITZ
Laureate 2001 for NORTH AMERICAPofessor of molecular Biological Sciences at Yale University (United States of America).For her discoveries of the structure, biological functions and pathological implications of small RNA molecules.
-
![MAYANNA ZATZ]() Mayanna ZATZ
Mayanna ZATZ
Laureate 2001 for LATIN AMERICA AND THE CARIBBEANProfessor of genetics University of Sao Paulo (Brazil).For her contributions to the pathology, diagnosis and management of hereditary.
-
![SUZANNE CORY]() Suzanne CORY
Suzanne CORY
Laureate 2001 for ASIA AND THE PACIFICProfessor at The Walter and Eliza Hall Institute of Medical Research, Melbourne (Australia).For her contributions to our understanding of the genetic basis of human lymphoma and other cancerous conditions.
-
![EUGENIA MARIA DEL PINO VEINTIMILLA]() Eugenia Maria Del Pino Veintimilla
Eugenia Maria Del Pino Veintimilla
Laureate 2000 for LATIN AMERICA AND THE CARIBBEANProfessor of developmental Biological Sciences at Pontifical Catholic University of Ecuador, Quito (Equateur).For her original investigations on the Biology of marsupial tree frogs and her efforts on behalf of conservation in the Galapagos Islands.
-
![JOANNE CHORY]() Joanne CHORY
Joanne CHORY
Laureate 2000 for NORTH AMERICAProfessor and Director Plant Molecular and Cellular Biological Sciences Laboratory Howard Hughes Medical Institute Investigator (United States).For her elucidation of the mechanisms involved in the response of plant organisms to light
-
![MARGARITA SALAS]() Margarita SALAS
Margarita SALAS
Laureate 2000 for EUROPEFor her fundamental contributions to our understanding of DNA replication.
-
![THRESSA CAMPBELL STADTMAN]() Thressa CAMPBELL STADTMAN
Thressa CAMPBELL STADTMAN
Laureate 2000 for NORTH AMERICABIOCHEMISTRY (United States).For her contributions to the epidemiology of cardiovascular disease in Africa.
-
![TUNEKO OKAZAKI]() Tuneko OKAZAKI
Tuneko OKAZAKI
Laureate 2000 for ASIA AND THE PACIFICProfessor of Molecular Biological Sciences at the Institute of Comprehensive Medical Science, Fujita Health Sciences University, Aichi (Japan).For her discovery of the molecular mechanism of retrograde DNA replication.
-
![VALÉRIE MIZRAHI]() Valérie MIZRAHI
Valérie MIZRAHI
Laureate 2000 for AFRICA AND THE ARAB STATESResearching at Molecular Mycobacteriology Research Unit, National Health Sciences Laboratory Service and University of the Witwatersrand (South Africa).For her contributions to the fight against tuberculosis and other infectious diseases.
-
![MONTENEGRO, Laureate 1998]() Gloria MONTENEGRO
Gloria MONTENEGRO
Laureate 1998 for LATIN AMERICA AND THE CARIBBEANProfessor of botanic at the Faculty of Agronomy and Forestry Sciences Pontificia Universidad Catolica de Chile, Santiago, (Chile).For her efforts to apply modern science to the protection of plant ecosystems.
-
![Grace Oladunni TAYLOR Laureate 1998]() Grace Oladunni TAYLOR
Grace Oladunni TAYLOR
Laureate 1998 for AFRICA AND THE ARAB STATESBiochemist, scholar, university professor (Nigeria).For her contributions to epidemiology cardio vascular disease in Africa.
-
![Pascale COSSART, Laureate 1998]() Pascale COSSART
Pascale COSSART
Laureate 1998 for EUROPEProfessor at Bacteria-Cell interaction Unit, Institut Pasteur, Paris, (France).For her elucidation of the mechanisms whereby pathogenic bacteria subvert immune defenses.
-
![YU MEONG-HEE, Laureate 1998]() Yu MEONG-HEE
Yu MEONG-HEE
Laureate 1998 for ASIA AND THE PACIFICResearcher and professor on micro Biological Sciences at Korean Institute of Science and Technology, Seoul, (South Korea).For her discoveries of protein folding and its relationship to human pathology.